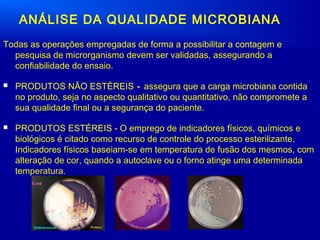
ANÁLISE DA QUALIDADE MICROBIANA
Todas as operações empregadas de forma a possibilitar a contagem e
pesquisa de microrganismo devem ser validadas, assegurando a
confiabilidade do ensaio.
 PRODUTOS NÃO ESTÉREIS - assegura que a carga microbiana contida
no produto, seja no aspecto qualitativo ou quantitativo, não compromete a
sua qualidade final ou a segurança do paciente.
 PRODUTOS ESTÉREIS - O emprego de indicadores físicos, químicos e
biológicos é citado como recurso de controle do processo esterilizante.
Indicadores físicos baseiam-se em temperatura de fusão dos mesmos, com
alteração de cor, quando a autoclave ou o forno atinge uma determinada
temperatura.

O documento discute o controle de qualidade de medicamentos, incluindo definições de medicamentos, formas farmacêuticas e categorias de registro na ANVISA. Também aborda procedimentos de controle de qualidade como validação de métodos analíticos, ensaios de qualidade e controle microbiológico.